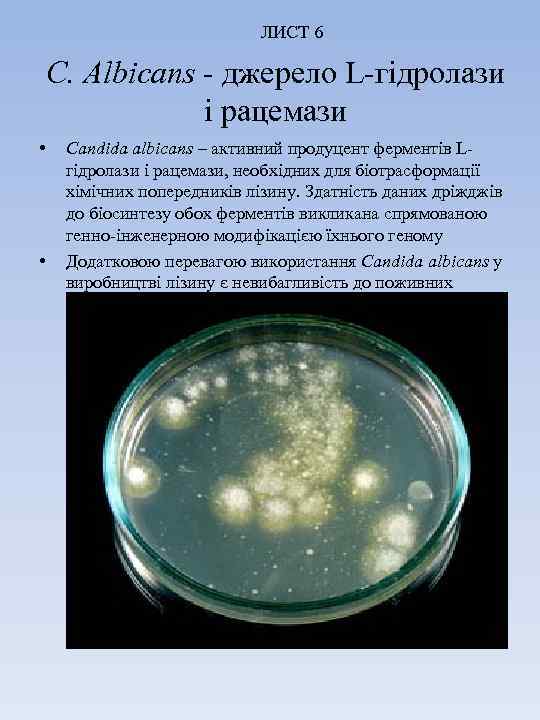
ЛИСТ 6 C. Albicans - джерело L-гідролази і рацемази • • Candida albicans –

Tkach_N_S-slaydi.ppt
- Количество слайдов: 11

Випускна кваліфікаційна робота бакалавра на тему: Аналіз сучасних технологій виробництва незамінних амінокислот з метою вибору оптимальної для умов України

ЛИСТ 2 Сучасний стан біотехнології амінокислот • Ринок амінокислот за даними Abercade consultіng, оцінюється в 2, 5 млрд. дол. /рік. Незважаючи на високі темпи розвитку мікробіологічної промисловості, потреба в амінокислотах поки задовольняється тільки на 25 - 30% • Найгостріше стоїть проблема з виробництвом незамінних амінокислот( валін, ізолейцин, лізин, метіонін, треонін, триптофан і фенілаланін), які лімітують засвоєння білкової складової їжі і тим самим визначають її поживну та фізіологічну цінність. • Серед незамінних амінокислот в світовому масштабі лізин синтезується в найбільших обсягах

ЛИСТ 3 Ø Об’єкт дослідження – технологія виробництва лізину Ø Мета роботи – аналіз існуючих технологій виробництва лізину з метою вибору оптимальної для умов України. Ø Задача роботи – охарактеризувати фізико-хімічні властивості лізину, визначити сферу використання амінокислоти, вибрати оптимальний спосіб виробництва лізину, охарактеризувати мікробіологічні основи виробництва, розробити процесуальну та технологічну схеми, розробити заходи по поліпшенню умов з охорони праці в цеху виробництва лізина.

Галузі застосування Lлізину • Харчова і фармацевтична промисловість • Хімічні дослідження • Медицина • Сільське господарство

ЛИСТ 5 Функції лізину в організмі людини • • • Імуномодулююча; Контроль синтезу гормонів ендокринної системи та ферментів травної системи; Регуляція транспорту кисню і поживних речовин; Підтримка тонусу серцевого м'яза; Забезпечення функції жовчного міхура; Попередження розвитку карієсу

Способи виробництва Lлізину

ЛИСТ 5 • • За допомогою комбінованого способу виробництва лізин отримують з 95% виходом і 99% оптичною чистотою, причому зміст амінокислоти в реакційній суміші може досягати 200 г / л, що практично більш ніж удвічі вище його змісту в культуральній рідині , одержуваної в одну стадію при направленому мікробіологічному синтезі в найкращих виробничих ферментаціях. Технологія процесу включає в себе органічний синтез D, L-а-аміно-ε-капролактаму з циклогексану і його ферментативний гідроліз з використанням двох ферментів - L-гідролази і рацемази. Перший селективно гідролізує D, L-а-аміно-ε-капролактам, другий здійснює рацемізацію L-гідролазою D-форми в L-форму
ЛИСТ 6 C. Albicans - джерело L-гідролази і рацемази • • Candida albicans – активний продуцент ферментів Lгідролази і рацемази, необхідних для біотрасформації хімічних попередників лізину. Здатність даних дріжджів до біосинтезу обох ферментів викликана спрямованою генно-інженерною модифікацією їхнього геному Додатковою перевагою використання Candida albicans у виробництві лізину є невибагливість до поживних речовин, високі продуктивність і швидкість росту

ЛИСТ 7 Процесуальна схема виробництва лізина

ЛИСТ 8 Технологічна схема виробництва лізина

ЛИСТ 9 Висновки • • • Охарактеризували фізико-хімічні властивості лізину; Визначили сферу використання амінокислоти; Виявили, що самим оптимальним способом виробництва лізину є ензиматичний спосіб; Охарактеризували мікробіологічні основи виробництва; Розробили процесуальну та технологічну схеми виробництва лізину; Описали заходи по поліпшенню умов з охорони праці в цеху виробництва лізина. в работе измените и сюда вставите
Tkach_N_S-slaydi.ppt